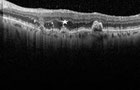
Link.

Contatti
Contattaci ai nostri INDIRIZZI

0742.353871
333.3880227
Social
Seguici sui nostri CANALI SOCIAL
Mappa
Trovaci su GOOGLE MAP
Servizi
Regala un BUONO!
Richiedi un controllo della vista a DOMICILIO
Ottieni il PAGAMENTO a RATE
...prossimamente attivo
Promo
Ottieni lo SCONTO 50% sul secondo occhiale
Altro

ORDINAZIONE OCCHIALI
Scarica il

Controlla i nostri BRAND

Guarda i nostri VIDEO

Il nostro BIGLIETTO DA VISITA
Vai al mio profilo personale FACEBOOK
Visita il nostro BLOG


Il CALENDARIO
OTTICA
CAMPAGNACCI
is authorized dealer of:

- Binocoli e cannocchiali
- Microscopi
- Strumenti elettronici meteo
- Altimetri e bussole
- Barometri, termometri e Galileiani
- Lenti d'ingrandimento
- Telescopi
- Visori notturni "Yukon"
- Strumenti "Suunto"
- Catalogo "C.A.I."

OTTICA CAMPAGNACCI aderisce alla raccolta degli occhiali usati:


 di Fabrizio Campagnacci
di Fabrizio Campagnacci